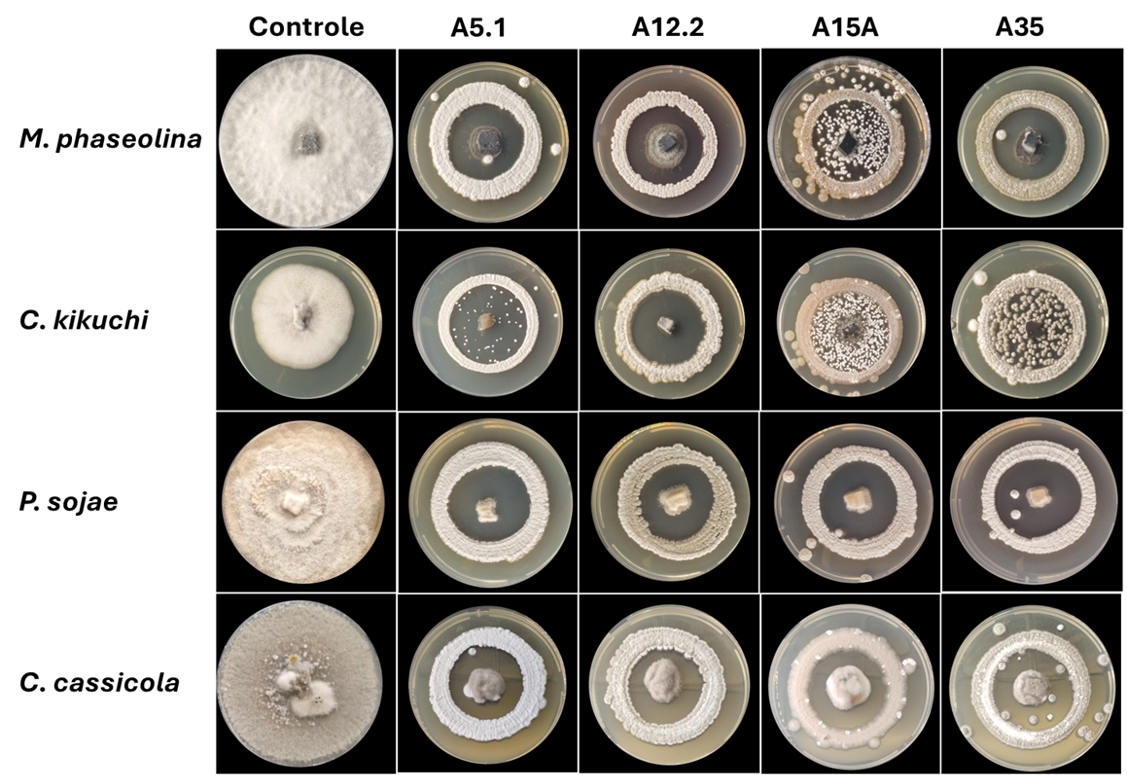

Estudo de Pós-graduação em Microbiologia Agrícola abre possibilidades para o manejo fitossanitário da soja
“A demanda por produtos biológicos, especialmente para grandes culturas como a soja, tem estimulado empresas e produtores a buscar soluções inovadoras para integrar ao manejo fitossanitário”
Pesquisas conduzidas na Escola Superior de Agricultura “Luiz de Queiroz” (Esalq/USP) estão abrindo novas perspectivas para o manejo sustentável de doenças da soja, uma das culturas mais importantes do agronegócio brasileiro. O engenheiro agrônomo Juan Lopes Teixeira, mestre pelo Programa de Pós-graduação em Microbiologia Agrícola da Esalq, sob orientação da professora Simone Possedente de Lira, do Departamento de Ciências Exatas, liderou um estudo pioneiro no desenvolvimento de fungicidas microbiológicos de primeira e terceira geração.
O trabalho surge em um contexto de crescimento acelerado do mercado de bioinsumos agrícolas no Brasil, que nos últimos cinco anos registrou expansão superior a 10% ao ano. “A demanda por produtos biológicos, especialmente para grandes culturas como a soja, tem estimulado empresas e produtores a buscar soluções inovadoras para integrar ao manejo fitossanitário”, aponta o pesquisador.
A pesquisa realizou a triagem de 20 cepas de Streptomyces spp., isoladas das ilhas de Alcatrazes e Palmas, no litoral paulista, com potencial antagonista a importantes fitopatógenos da soja. Entre as doenças-alvo estão a mancha-alvo (Corynespora cassiicola), a podridão seca da haste e da vagem (Phomopsis sojae), a podridão de carvão da raiz (Macrophomina phaseolina) e a mancha púrpura da semente (Cercospora kikuchii).
Segundo Juan Teixeira, duas inovações se destacam no projeto. “Na primeira geração, a utilização de células vivas de Streptomyces spp. no desenvolvimento de produtos biológicos — algo inédito no Brasil e presente em menos de 15 produtos no mundo. Na terceira geração, o emprego de metabólitos secundários desses microrganismos para o controle de doenças, com resultados promissores de eficácia”, detalha o autor.
Dos testes realizados, quatro cepas foram selecionadas para avançar no desenvolvimento de fungicidas de primeira geração, e uma cepa foi escolhida para a produção de um produto de terceira geração. Os resultados in vitro indicaram níveis de controle superiores a 53% em cultivos paralelos e acima de 88% em cultivos cercados. Para os metabólitos secundários, o controle ultrapassou 84%, com perfis cromatográficos diferenciados em relação ao controle.
Segundo Juan Lopes Teixeira, esses resultados contribuem para uma agricultura mais regenerativa e ajudam a reduzir a pressão de seleção de patógenos resistentes a fungicidas químicos. “Os biológicos podem atuar de forma complementar, proporcionando maior sustentabilidade no manejo de doenças e preservando a eficácia das moléculas sintéticas”, afirma.
O estudo contou com financiamento da FAPESP (Processo nº 2019/17721-9) e bolsa de mestrado concedida pela CAPES (Processo nº 88887.822602/2023-00). Neste vídeo, gravado para o projeto Construindo Ciência, o pesquisador fala um pouco mais sobre o projeto.